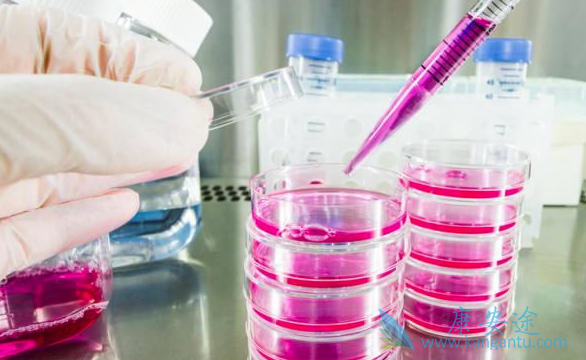
治疗丙肝最好的医院 治疗丙肝最好的医院

丙肝是我们生活中常见的传染性肝病之一,很多朋友在发现丙肝的时候,就已经被成了肝硬化,它的出现给患者及身边的家人朋友都造成极大的威胁,因此我们要积极的治疗。然而面对市面上众多的医院,我们该如何选择好的治疗丙肝医院呢?今天小编就为大家介绍下治疗丙肝最好的医院该如何选择吧!治疗丙肝的医院该如何选择?
谨防虚假广告宣传。在选择医院时患者一定要分清,不要陷入虚假宣传的陷阱,由于是一些没有医疗资质的诊所或个人打着各种口号,如“一个月治愈肝病”、“肝病药”之类,进行夸大的虚假宣传,使患者无法辨别。因此患者在治疗丙肝一定要注意不能轻信虚假广告。2、选择专业的肝病医院。由于丙肝的严重性和传染性,患者者一定要选择一家好医院治疗,以保证早日康复,避免病情的恶化和传染,到技术好、设备先进齐全、口碑好的医院。患者不要一味的追求医院的资质,总之最重要的还是要选择正确的治疗方法,医院选择,重要技术和口碑。3、选择合理收费的医院。专家团队,技术设备,优质的人文服务,配合公正合理的医疗收费,才能构成一个肝病医院,所以收费的合理性也是判断一家丙肝医院正规与否4、选择专业的肝病专家。选择一家好的丙肝医院要选择有肝病专家的医院,在选择时,要看院内有多少肝病专家,专家职称和治疗肝病的专业性来判断。有专业的医师治疗才能更好的保证肝病的治疗效果和患者的康复信心。
选择具有先进的技术设备的医院。技术设备是硬性支撑,缺少专业的诊疗设备做支撑,经验再丰富、知识再专业的专家都会无用武之地,只有专家的专业技术配上先进的诊疗技术才丙肝的早期症状有哪些?1、慢性丙肝患者的丙肝早期的症状也不明显,患者可无症状地发展数年。事实上,人们往往在偶然情况下知道自己得了丙肝,如在对高危人群进行普查时,也可是在输血前的常规检查时,也可在申请医疗保险体检时。2、慢性丙肝患者丙肝早期的症状常有轻重不一的乏力,有时可影响患者的工作和日常生活。其次可表现为右上腹不适,患者常自诉右上腹有沉重感。其他一些丙肝早期的症状包括恶心和关节痛,黄疸很少发生。值得注意的是治疗丙肝早期的症状的有无或其严重程度与肝脏病变的发展不成正比。3、丙肝的急性期丙肝早期的症状往往不容易被发现,因为大多数患者丙肝早期的症状往往不明显,即使有也不特异,可表现为流感样症状,例如胃口不好、感觉很累、恶心、呕吐等丙肝早期的症状,有时会发生黄疸。有极少的急性丙肝会引起严重致命的肝功能衰竭。
详情请访问 丙肝 https://www.kangantu.com/














请简单描述您的疾病情况,我们会有专业的医学博士免费为您解答问题(24小时内进行电话回访)